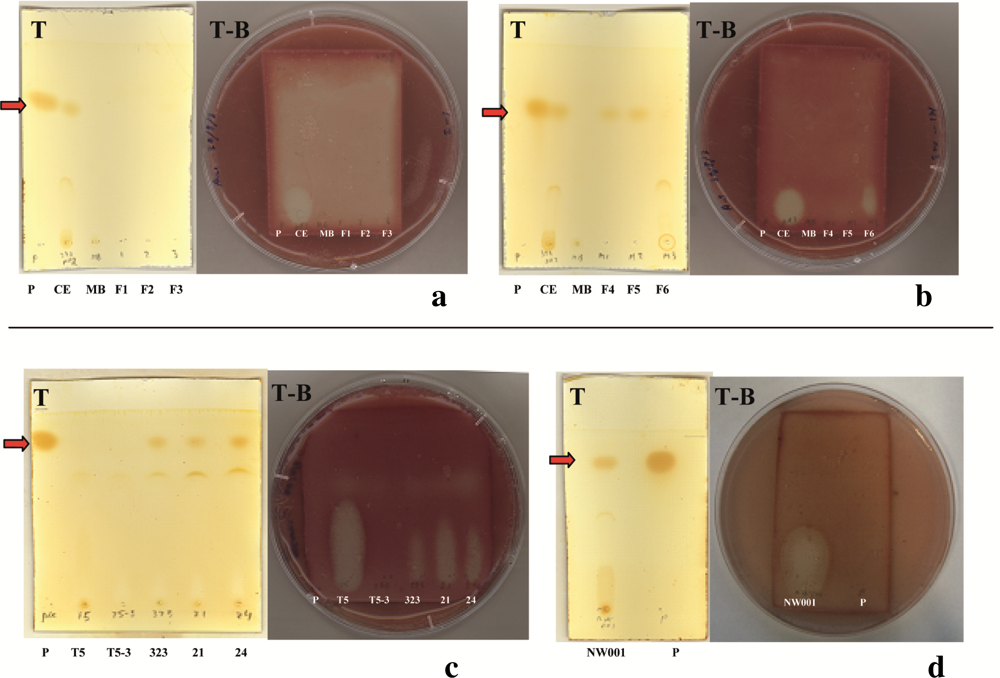
Marinedrugs 09 01391f3

Identification of the Antibacterial Compound Produced by the Marine Epiphytic Bacterium Pseudovibrio sp. D323 and Related Sponge-Associated Bacteria
Abstract
:1. Introduction
2. Results and Discussion
2.1. Isolate D323 Is a Representative of a Widespread, Surface-Associated Alphaproteobacteria Clade
2.2. Identification of Antibacterial Secondary Metabolites in D323 and Related Strains
2.3. TDA Inhibits a Variety of Marine Bacteria but Shows No Auto-Inhibition in Producer Strains
3. Experimental Section
3.1. Bacterial Strains and Culture Conditions
3.2. 16S rRNA Gene Sequencing and Analysis
3.3. Antibacterial Assays and Preparation of Crude Antibacterial Extracts
3.4. Gas-Chromatography Mass-Spectrometry (GC-MS)
3.5. Thin Layer Chromatography (TLC) and TLC-Bioautography Overlay Assay (TLC-BOA)
3.6. Purification of the Antibacterial Compound
4. Conclusions
Supplementary Material
marinedrugs-09-01391-s001.pdfAcknowledgments
- Samples Availability: Available from the authors.
References
- Clardy, J; Fischbach, MA; Walsh, CT. New antibiotics from bacterial natural products. Nat. Biotechnol. 2006, 24, 1541–1550. [Google Scholar]
- Penesyan, A; Kjelleberg, S; Egan, S. Development of novel drugs from marine surface associated microorganisms. Mar. Drugs 2010, 8, 438–459. [Google Scholar]
- Armstrong, E; Yan, L; Boyd, KG; Wright, PC; Burgess, JG. The symbiotic role of marine microbes on living surfaces. Hydrobiologia 2001, 461, 37–40. [Google Scholar]
- Egan, S; Thomas, T; Kjelleberg, S. Unlocking the diversity and biotechnological potential of marine surface associated microbial communities. Curr. Opin. Microbiol. 2008, 11, 219–225. [Google Scholar]
- Longford, SR. The ecology of epiphytic bacteria on the marine red alga Delisea pulchra. Ph.D. Thesis, Biology, Earth & Environmental Sciences, Faculty of Science, University of New South Wales, Sydney, Australia,. 2008. [Google Scholar]
- Penesyan, A; Marshall-Jones, Z; Holmstrom, C; Kjelleberg, S; Egan, S. Antimicrobial activity observed among cultured marine epiphytic bacteria reflects their potential as a source of new drugs. FEMS Microbiol. Ecol. 2009, 69, 113–124. [Google Scholar]
- Fukunaga, Y; Kurahashi, M; Tanaka, K; Yanagi, K; Yokota, A; Harayama, S. Pseudovibrio ascidiaceicola sp. nov., isolated from ascidians (sea squirts). Int. J. Syst. Evol. Microbiol. 2006, 56, 343–347. [Google Scholar]
- Webster, NS; Hill, RT. The culturable microbial community of the great barrier reef sponge Rhopaloeides odorabile is dominated by an alpha-Proteobacterium. Mar. Biol. 2001, 138, 843–851. [Google Scholar]
- Enticknap, JJ; Kelly, M; Peraud, O; Hill, RT. Characterization of a culturable alphaproteobacterial symbiont common to many marine sponges and evidence for vertical transmission via sponge larvae. Appl. Environ. Microbiol. 2006, 72, 3724–3732. [Google Scholar]
- Muscholl-Silberhorn, A; Thiel, V; Imhoff, J. Abundance and bioactivity of cultured sponge-sssociated bacteria from the Mediterranean sea. Microb. Ecol. 2008, 55, 94–106. [Google Scholar]
- Sertan-De Guzman, AA; Predicala, RZ; Bernardo, EB; Neilan, BA; Elardo, SP; Mangalindan, GC; Tasdemir, D; Ireland, CM; Barraquio, WL; Concepcion, GP. Pseudovibrio denitrificans strain Z143-1, a heptylprodigiosin-producing bacterium isolated from a Philippine tunicate. FEMS Microbiol. Lett. 2007, 277, 188–196. [Google Scholar]
- Geng, H; Belas, R. Expression of tropodithietic acid biosynthesis is controlled by a novel autoinducer. J. Bacteriol. 2010, 192, 4377–4387. [Google Scholar]
- Thiel, V; Imhoff, JF. Phylogenetic identification of bacteria with antimicrobial activities isolated from Mediterranean sponges. Biomol. Eng. 2003, 20, 421–423. [Google Scholar]
- Lafi, FF; Garson, MJ; Fuerst, JA. Culturable bacterial symbionts isolated from two distinct sponge species (Pseudoceratina clavata and Rhabdastrella globostellata) from the Great Barrier Reef display similar phylogenetic diversity. Microb. Ecol. 2005, 50, 213–220. [Google Scholar]
- Webster, NS; Cobb, RE; Negri, AP. Temperature thresholds for bacterial symbiosis with a sponge. ISME J. 2008, 2, 830–842. [Google Scholar]
- Muller, WEG; Grebenjuk, VA; Thakur, NL; Thakur, AN; Batel, R; Krasko, A; Muller, IM; Breter, HJ. Oxygen-controlled bacterial growth in the sponge Suberites domuncula: Toward a molecular understanding of the symbiotic relationships between sponge and bacteria. Appl. Environ. Microbiol. 2004, 70, 2332–2341. [Google Scholar]
- Liang, I. Investigation of secondary metabolites of North Sea bacteria: Fermentation, isolation, structure elucidation and bioactivity. Ph.D. Thesis, University of Gottingen, Gottingen, Germany,. 2003. [Google Scholar]
- Bruhn, JB; Nielsen, KF; Hjelm, M; Hansen, M; Bresciani, J; Schulz, S; Gram, L. Ecology, inhibitory activity, and morphogenesis of a marine antagonistic bacterium belonging to the Roseobacter clade. Appl. Environ. Microbiol. 2005, 71, 7263–7270. [Google Scholar]
- Brinkhoff, T; Bach, G; Heidorn, T; Liang, L; Schlingloff, A; Simon, M. Antibiotic production by a Roseobacter clade-affiliated species from the German Wadden Sea and its antagonistic effects on indigenous isolates. Appl. Environ. Microbiol. 2004, 70, 2560–2565. [Google Scholar]
- Martens, T; Heidorn, T; Pukall, R; Simon, M; Tindall, BJ; Brinkhoff, T. Reclassification of Roseobacter gallaeciensis Ruiz-Ponte et al. 1998 as Phaeobacter gallaeciensis gen. nov., comb. nov., description of Phaeobacter inhibens sp. nov., reclassification of Ruegeria algicola (Lafay et al. 1995) Uchino et al. 1999 as Marinovum algicola gen. nov., comb. nov., and emended descriptions of the genera Roseobacter, Ruegeria and Leisingera. Int. J. Syst. Evol. Microbiol. 2006, 56, 1293–1304. [Google Scholar]
- Porsby, CH; Nielsen, KF; Gram, L. Phaeobacter and Ruegeria species of the Roseobacter clade colonize separate niches in a Danish turbot (Scophthalmus maximus)-rearing farm and antagonize Vibrio anguillarum under different growth conditions. Appl. Environ. Microbiol. 2008, 74, 7356–7364. [Google Scholar]
- Thiel, V; Brinkhoff, T; Dickschat, JS; Wickel, S; Grunenberg, J; Wagner-Döbler, I; Simon, M; Schulz, S. Identification and biosynthesis of tropone derivatives and sulfur volatiles produced by bacteria of the marine Roseobacter clade. Org. Biomol. Chem. 2010, 8, 234–246. [Google Scholar]
- Kawamoto, M. Production, absorption and excretion of phenols in intestinal obstruction. Nippon Geka Gakkai Zasshi 1986, 87, 1426–1431. [Google Scholar]
- Katayama, T; Suzuki, H; Koyanagi, T; Kumagai, H. Cloning and random mutagenesis of the Erwinia herbicola tyrR gene for high-level expression of tyrosine phenol-lyase. Appl. Environ. Microbiol. 2000, 66, 4764–4771. [Google Scholar]
- Lloyd-George, I; Chang, TMS. Free and microencapsulated Erwinia herbicola for the production of tyrosine: Kinetic characterization of intracellular tyrosine phenol-lyase. Artif. Cells Blood Substit. Immobil. Biotechnol. 1993, 21, 323–333. [Google Scholar]
- Lutke-Eversloh, T; Santos, CNS; Stephanopoulos, G. Perspectives of biotechnological production of l-tyrosine and its applications. Appl. Microbiol. Biotechnol. 2007, 77, 751–762. [Google Scholar]
- Liu, H; Namikoshi, M; Meguro, S; Nagai, H; Kobayashi, H; Yao, X. Isolation and characterization of polybrominated diphenyl ethers as inhibitors of microtubule assembly from the marine sponge Phyllospongia dendyi collected at Palau. J. Nat. Prod. 2004, 67, 472–474. [Google Scholar]
- Onofrejova, L; Vasíckova, J; Klejdus, B; Stratil, P; Misurcova, L; Kracmar, S; Kopecky, J; Vacek, J. Bioactive phenols in algae: The application of pressurized-liquid and solid-phase extraction techniques. J. Pharm. Biomed. Anal. 2010, 51, 464–470. [Google Scholar]
- Zhang, H; Skildum, A; Stromquist, E; Rose-Hellekant, T; Chang, LC. Bioactive polybrominated diphenyl ethers from the marine sponge Dysidea sp. J. Nat. Prod. 2008, 71, 262–264. [Google Scholar]
- Le, QT; Li, Y; Qian, ZJ; Kim, MM; Kim, SK. Inhibitory effects of polyphenols isolated from marine alga Ecklonia cava on histamine release. Process Biochem. 2009, 44, 168–176. [Google Scholar]
- Calcul, L; Chow, R; Oliver, AG; Tenney, K; White, KN; Wood, AW; Fiorilla, C; Crews, P. NMR strategy for unraveling structures of bioactive sponge-derived oxy-polyhalogenated diphenyl ethers. J. Nat. Prod. 2009, 72, 443–449. [Google Scholar]
- Bauer, AW; Kirby, WM; Sherris, JC; Turck, M. Antibiotic susceptibility testing by a standardized single disk method. Am. J. Clin. Pathol. 1966, 45, 493–496. [Google Scholar]
- Bruhn, JB; Gram, L; Belas, R. Production of antibacterial compounds and biofilm formation by Roseobacter species are influenced by culture conditions. Appl. Environ. Microbiol. 2007, 73, 442–450. [Google Scholar]
- Geng, H; Bruhn, JB; Nielsen, KF; Gram, L; Belas, R. Genetic dissection of tropodithietic acid biosynthesis by marine roseobacters. Appl. Environ. Microbiol. 2008, 74, 1535–1545. [Google Scholar]
- Case, RJ; Longford, SR; Campbell, AH; Low, A; Tujula, N; Steinberg, PD; Kjelleberg, S. Temperature induced bacterial virulence and bleaching disease in a chemically defended marine macroalga. Environ. Microbiol. 2011, 13, 529–537. [Google Scholar]
- Yung, M. University of New South Wales, Sydney, Australia. Unpublished work,. 2010.
- Lane, DJ. 16S/23S rRNA sequencing. In Nucleic Acid Techniques in Bacterial Systematics; Stackebrandt, E, Goodfellow, M, Eds.; John Wiley & Sons: New York, NY, USA, 1991; pp. 115–147. [Google Scholar]
- Stackebrandt, E; Liesack, W. Nucleic acids and classification. In Handbook of New Bacterial Systematics; Goodfellow, M, O’Donnell, AG, Eds.; Academic Press: London, UK, 1993; pp. 152–189. [Google Scholar]
- Vossbrinck, CR; Baker, MD; Didier, ES; Debrunner-Vossbrinck, BA; Shadduck, JA. Ribosomal DNA sequences of Encephalitozoon hellem and Encephalitozoon cuniculi: Species identification and phylogenetic construction. J. Eukaryot. Microbiol. 1993, 40, 354–362. [Google Scholar]
- Ludwig, W; Strunk, O; Westram, R; Richter, L; Meier, H; Yadhukumar, A; Buchner, A; Lai, T; Steppi, S; Jacob, G; et al. ARB: A software environment for sequence data. Nucleic Acids Res. 2004, 32, 1363–1371. [Google Scholar]
- Neidhard, FC; Bloch, PL; Smith, DF. Culture medium for enterobacteria. J. Bacteriol. 1974, 119, 736–747. [Google Scholar]
- Hamburger, MO; Cordell, GA. A direct bioautographic TLC assay for compounds possessing antibacterial activity. J. Nat. Prod. 1987, 50, 19–22. [Google Scholar]

| Target Strains | Phylum | Origin | Inhibition by TDA |
|---|---|---|---|
| Alpha-proteobacterium D323 ^ | Alphaproteobacteria | seaweed Delisea pulchra | − |
| Phaeobacter inhibens T5 ^ | Alphaproteobacteria | marine sediment | − |
| Phaeobacter inhibens T5-3 | Alphaproteobacteria | marine sediment | − |
| Nautella sp. R11 | Alphaproteobacteria | seaweed Delisea pulchra | +++ |
| Phaeobacter gallaeciensis 2.10 ^ | Alphaproteobacteria | seaweed Ulva lactuca | − |
| Oceanicola granulosus | Alphaproteobacteria | seawater | ++ |
| Oceanicola batsensis | Alphaproteobacteria | seawater | +++ |
| Roseovarius sp. 2601 | Alphaproteobacteria | seawater | ++ |
| Oceanicaulis alexandrii | Alphaproteobacteria | seawater | ++ |
| Rhodobacterales bacterium | Alphaproteobacteria | seawater | +++ |
| Phaeobacter gallaeciensis BS107 ^ | Alphaproteobacteria | scallop Pecten maximus | − |
| Vibrio harveyi | Gammaproteobacteria | seawater | +++ |
| Pseudoalteromonas tunicata | Gammaproteobacteria | tunicate Ciona intestinalis | +++ |
| Pseudoalteromonas undina | Gammaproteobacteria | seawater | ++ |
| Pseudoalteromonas piscicida | Gammaproteobacteria | dead fish | + |
| Pseudoalteromonas citrea | Gammaproteobacteria | seawater | ++ |
| Pseudoalteromonas haloplanktis | Gammaproteobacteria | oyster Crassostrea gigas | ++ |
| Pseudoalteromonas ulvae | Gammaproteobacteria | seaweed Ulva lactuca | ++ |
| Pseudoalteromonas flavipulchra | Gammaproteobacteria | seawater | + |
| Acinetobacter sp. ESS07 | Gammaproteobacteria | seaweed Delisea pulchra | +++ |
| Marinomonas sp. ND73 | Gammaproteobacteria | seaweed Delisea pulchra | +++ |
| Shewanella sp. ND51 | Gammaproteobacteria | seaweed Delisea pulchra | ++ |
| Thalassomonas sp. ND29 | Gammaproteobacteria | seaweed Delisea pulchra | +++ |
| Thalassomonas sp. ND49 | Gammaproteobacteria | seaweed Delisea pulchra | ++ |
| Aestuariibacter sp. ND16 | Gammaproteobacteria | seaweed Delisea pulchra | ++ |
| Vibrio sp. ND23 | Gammaproteobacteria | seaweed Delisea pulchra | ++ |
| Dokdonia sp. ESS16 | Bacteroidetes | seaweed Delisea pulchra | ++ |
| Aquimarina sp. ND19 | Bacteroidetes | seaweed Delisea pulchra | + |
| Tenacibaculum sp. ND71 | Bacteroidetes | seaweed Delisea pulchra | + |
| Bacillus sp. D203 | Firmicutes | seaweed Delisea pulchra | ++ |
| Bacillus sp. ESS03 | Firmicutes | seaweed Delisea pulchra | +++ |
| Micrococcus sp. ESS26 | Actinobacteria | seaweed Delisea pulchra | ++ |
| Agrococcus sp. LSS27 | Actinobacteria | seaweed Delisea pulchra | ++ |
© 2011 by the authors; licensee MDPI, Basel, Switzerland. This article is an open access article distributed under the terms and conditions of the Creative Commons Attribution license (http://creativecommons.org/licenses/by/3.0/).
Share and Cite
Penesyan, A.; Tebben, J.; Lee, M.; Thomas, T.; Kjelleberg, S.; Harder, T.; Egan, S. Identification of the Antibacterial Compound Produced by the Marine Epiphytic Bacterium Pseudovibrio sp. D323 and Related Sponge-Associated Bacteria. Mar. Drugs 2011, 9, 1391-1402. https://doi.org/10.3390/md9081391
Penesyan A, Tebben J, Lee M, Thomas T, Kjelleberg S, Harder T, Egan S. Identification of the Antibacterial Compound Produced by the Marine Epiphytic Bacterium Pseudovibrio sp. D323 and Related Sponge-Associated Bacteria. Marine Drugs. 2011; 9(8):1391-1402. https://doi.org/10.3390/md9081391
Chicago/Turabian StylePenesyan, Anahit, Jan Tebben, Matthew Lee, Torsten Thomas, Staffan Kjelleberg, Tilmann Harder, and Suhelen Egan. 2011. "Identification of the Antibacterial Compound Produced by the Marine Epiphytic Bacterium Pseudovibrio sp. D323 and Related Sponge-Associated Bacteria" Marine Drugs 9, no. 8: 1391-1402. https://doi.org/10.3390/md9081391
APA StylePenesyan, A., Tebben, J., Lee, M., Thomas, T., Kjelleberg, S., Harder, T., & Egan, S. (2011). Identification of the Antibacterial Compound Produced by the Marine Epiphytic Bacterium Pseudovibrio sp. D323 and Related Sponge-Associated Bacteria. Marine Drugs, 9(8), 1391-1402. https://doi.org/10.3390/md9081391




